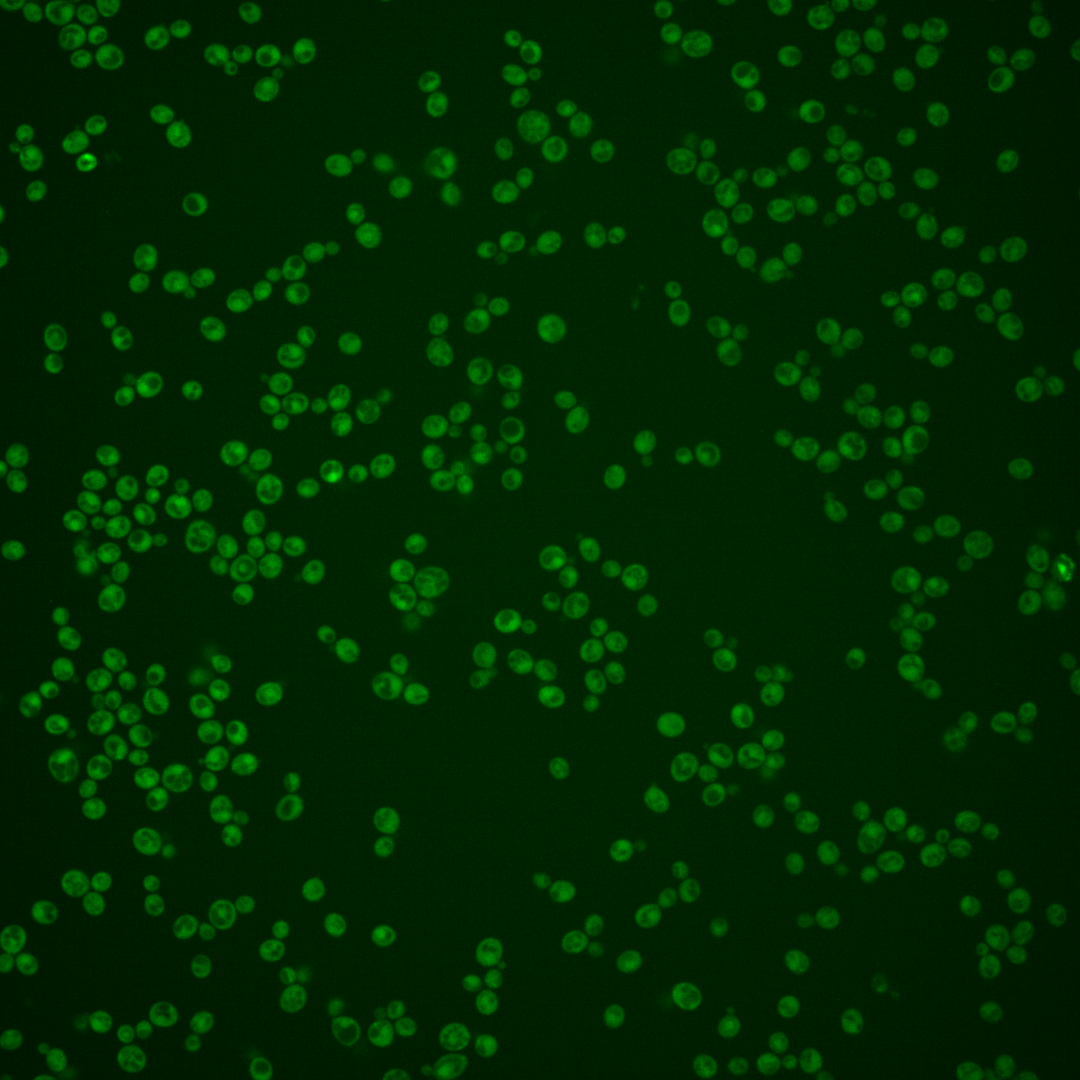
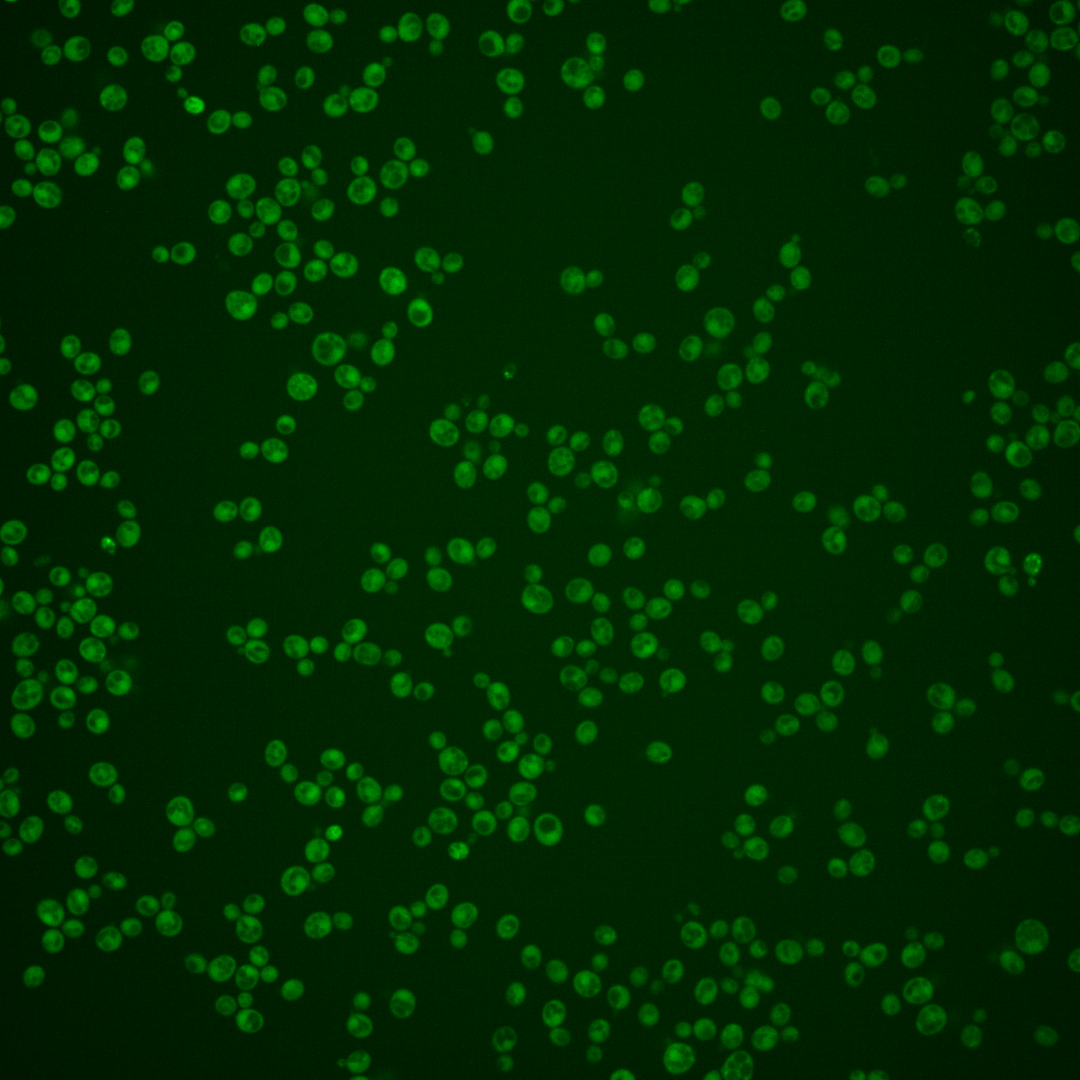
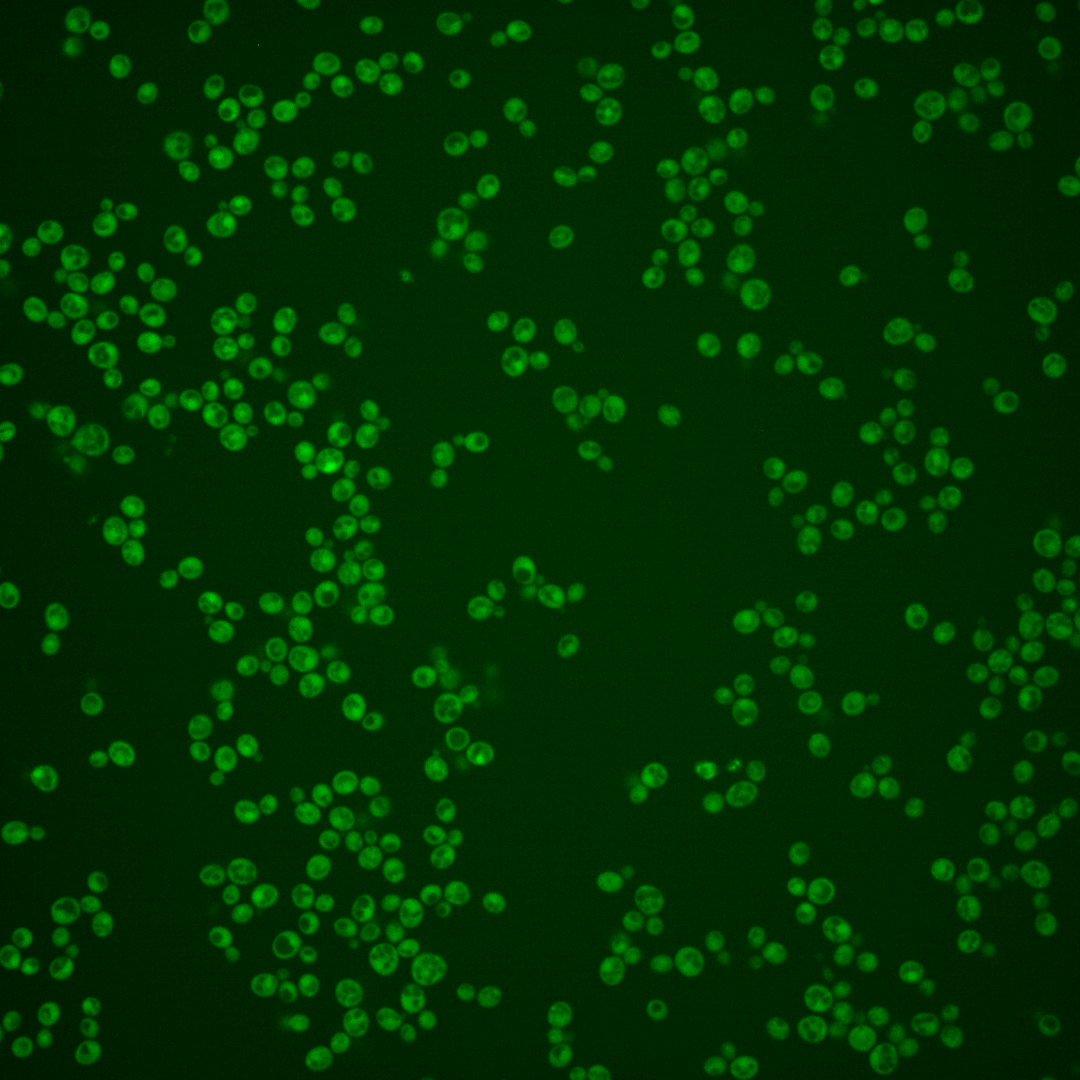

| Standard name | |
|---|---|
| Human Ortholog | |
| Description | Protein of unknown function; contains sequence that closely resembles a J domain (typified by the E. coli DnaJ protein) |
Micrographs




















































































Sub-cellular Localization
Yeast GFP Assignment
Protein Abundance
Localization Change
External localization resources
| ensLOC | DeepLoc | |||||||||||||||||||||||
|---|---|---|---|---|---|---|---|---|---|---|---|---|---|---|---|---|---|---|---|---|---|---|---|---|
| Localization | WT1 | WT2 | WT3 | RAP60 | RAP140 | RAP220 | RAP300 | RAP380 | RAP460 | RAP540 | RAP620 | RAP700 | HU80 | HU120 | HU160 | rpd3Δ_1 | rpd3Δ_2 | rpd3Δ_3 | WT1 | WT2 | WT3 | AF100 | AF140 | AF180 |
| Cortical Patches | 0 | 0 | 0 | 0 | 0 | 0 | 0 | – | 0 | 1 | 1 | 0 | 0 | 0 | 0 | 0 | 0 | 0 | 1 | 0 | 0 | 1 | 0 | 1 |
| Bud | 0 | 0 | 0 | 0 | 0 | 0 | 1 | – | 2 | 3 | 7 | 6 | 0 | 1 | 1 | 1 | 0 | 0 | 0 | 0 | 0 | 2 | 1 | 8 |
| Bud Neck | 0 | 0 | 1 | 0 | 1 | 0 | 1 | – | 0 | 1 | 2 | 0 | 0 | 0 | 0 | 0 | 0 | 0 | 0 | 0 | 0 | 0 | 0 | 0 |
| Bud Site | 0 | 0 | 0 | 0 | 0 | 0 | 0 | – | 0 | 0 | 1 | 0 | 0 | 0 | 0 | 0 | 0 | 0 | – | – | – | – | – | – |
| Cell Periphery | 0 | 0 | 1 | 1 | 1 | 1 | 3 | – | 4 | 4 | 3 | 1 | 0 | 0 | 2 | 4 | 10 | 8 | 0 | 0 | 0 | 0 | 0 | 0 |
| Cytoplasm | 287 | 148 | 97 | 216 | 342 | 266 | 426 | – | 258 | 334 | 258 | 272 | 170 | 391 | 459 | 298 | 200 | 259 | 280 | 145 | 105 | 229 | 277 | 333 |
| Endoplasmic Reticulum | 1 | 0 | 0 | 0 | 0 | 1 | 0 | – | 0 | 0 | 1 | 1 | 1 | 0 | 1 | 17 | 11 | 15 | 0 | 0 | 0 | 1 | 4 | 1 |
| Endosome | 0 | 0 | 0 | 0 | 0 | 0 | 0 | – | 2 | 2 | 1 | 2 | 0 | 0 | 0 | 2 | 0 | 1 | 4 | 1 | 1 | 1 | 1 | 6 |
| Golgi | 0 | 1 | 0 | 0 | 1 | 0 | 0 | – | 0 | 0 | 0 | 0 | 0 | 0 | 2 | 1 | 0 | 1 | 3 | 3 | 0 | 0 | 2 | 2 |
| Mitochondria | 1 | 4 | 0 | 2 | 4 | 39 | 25 | – | 75 | 122 | 158 | 144 | 1 | 4 | 1 | 4 | 2 | 2 | 2 | 1 | 1 | 1 | 5 | 6 |
| Nucleus | 0 | 0 | 3 | 0 | 0 | 3 | 2 | – | 3 | 4 | 4 | 6 | 0 | 0 | 0 | 1 | 0 | 2 | 0 | 0 | 0 | 0 | 0 | 1 |
| Nuclear Periphery | 0 | 0 | 0 | 0 | 0 | 0 | 0 | – | 1 | 2 | 0 | 1 | 0 | 0 | 0 | 2 | 1 | 0 | 0 | 0 | 0 | 0 | 0 | 0 |
| Nucleolus | 0 | 0 | 0 | 0 | 1 | 1 | 1 | – | 0 | 0 | 0 | 0 | 0 | 0 | 0 | 1 | 0 | 0 | 0 | 0 | 0 | 0 | 0 | 0 |
| Peroxisomes | 0 | 0 | 0 | 0 | 0 | 0 | 0 | – | 0 | 0 | 1 | 0 | 0 | 0 | 0 | 0 | 0 | 0 | 0 | 0 | 0 | 0 | 0 | 0 |
| SpindlePole | 1 | 0 | 0 | 0 | 0 | 0 | 3 | – | 3 | 3 | 1 | 2 | 0 | 0 | 0 | 0 | 0 | 0 | 1 | 0 | 0 | 1 | 1 | 4 |
| Vac/Vac Membrane | 8 | 0 | 0 | 0 | 10 | 4 | 19 | – | 12 | 17 | 15 | 8 | 1 | 0 | 1 | 5 | 3 | 5 | 1 | 1 | 0 | 1 | 1 | 4 |
| Unique Cell Count | 297 | 151 | 99 | 217 | 352 | 286 | 452 | 305 | 422 | 361 | 369 | 172 | 392 | 460 | 309 | 205 | 267 | 297 | 157 | 111 | 244 | 301 | 377 | |
| Labelled Cell Count | 298 | 153 | 102 | 219 | 360 | 315 | 481 | 360 | 493 | 453 | 443 | 173 | 396 | 467 | 336 | 227 | 293 | 297 | 157 | 111 | 244 | 301 | 377 | |
Yeast GFP Assignment
Protein Abundance
| Screen | WT1 | WT2 | WT3 | RAP60 | RAP140 | RAP220 | RAP300 | RAP380 | RAP460 | RAP540 | RAP620 | RAP700 | HU80 | HU120 | HU160 | rpd3Δ_1 | rpd3Δ_2 | rpd3Δ_3 | AF100 | AF140 | AF180 |
|---|---|---|---|---|---|---|---|---|---|---|---|---|---|---|---|---|---|---|---|---|---|
| Mean Cell GFP Intensity (1e-4) | 5.0 | 5.3 | 6.1 | 5.4 | 6.2 | 4.7 | 5.1 | – | 4.5 | 4.3 | 4.0 | 4.1 | 5.5 | 4.8 | 5.7 | 5.9 | 6.5 | 6.4 | 5.6 | 5.3 | 5.4 |
| Std Deviation (1e-4) | 0.7 | 0.8 | 2.7 | 1.2 | 1.7 | 2.8 | 1.5 | – | 1.7 | 1.0 | 0.9 | 0.9 | 1.5 | 1.3 | 1.6 | 1.0 | 1.4 | 1.4 | 3.7 | 1.7 | 1.8 |
| Intensity Change (Log2) | – | – | – | -0.18 | 0.02 | -0.39 | -0.27 | – | -0.44 | -0.5 | -0.6 | -0.57 | -0.15 | -0.35 | -0.1 | -0.05 | 0.08 | 0.07 | -0.12 | -0.2 | -0.18 |
Localization Change
| Localization | RAP60 | RAP140 | RAP220 | RAP300 | RAP380 | RAP460 | RAP540 | RAP620 | RAP700 | HU80 | HU120 | HU160 | rpd3Δ_1 | rpd3Δ_2 | rpd3Δ_3 |
|---|---|---|---|---|---|---|---|---|---|---|---|---|---|---|---|
| Cortical Patches | 0 | 0 | 0 | 0 | – | 0 | 0 | 0 | 0 | 0 | 0 | 0 | 0 | 0 | 0 |
| Bud | 0 | 0 | 0 | 0 | – | 0 | 0 | 0 | 0 | 0 | 0 | 0 | 0 | 0 | 0 |
| Bud Neck | 0 | 0 | 0 | 0 | – | 0 | 0 | 0 | 0 | 0 | 0 | 0 | 0 | 0 | 0 |
| Bud Site | 0 | 0 | 0 | 0 | – | 0 | 0 | 0 | 0 | 0 | 0 | 0 | 0 | 0 | 0 |
| Cell Periphery | 0 | 0 | 0 | 0 | – | 0 | 0 | 0 | 0 | 0 | 0 | 0 | 0 | 0 | 0 |
| Cytoplasm | 1.3 | -0.4 | -1.8 | -1.5 | – | -3.5 | -4.5 | -5.6 | -5.2 | 0.6 | 2.0 | 2.2 | -0.8 | -0.2 | -0.5 |
| Endoplasmic Reticulum | 0 | 0 | 0 | 0 | – | 0 | 0 | 0 | 0 | 0 | 0 | 0 | 0 | 0 | 0 |
| Endosome | 0 | 0 | 0 | 0 | – | 0 | 0 | 0 | 0 | 0 | 0 | 0 | 0 | 0 | 0 |
| Golgi | 0 | 0 | 0 | 0 | – | 0 | 0 | 0 | 0 | 0 | 0 | 0 | 0 | 0 | 0 |
| Mitochondria | 0 | 0 | 0 | 0 | – | 0 | 0 | 0 | 0 | 0 | 0 | 0 | 0 | 0 | 0 |
| Nucleus | 0 | 0 | 0 | 0 | – | 0 | 0 | 0 | 0 | 0 | 0 | 0 | 0 | 0 | 0 |
| Nuclear Periphery | 0 | 0 | 0 | 0 | – | 0 | 0 | 0 | 0 | 0 | 0 | 0 | 0 | 0 | 0 |
| Nucleolus | 0 | 0 | 0 | 0 | – | 0 | 0 | 0 | 0 | 0 | 0 | 0 | 0 | 0 | 0 |
| Peroxisomes | 0 | 0 | 0 | 0 | – | 0 | 0 | 0 | 0 | 0 | 0 | 0 | 0 | 0 | 0 |
| SpindlePole | 0 | 0 | 0 | 0 | – | 0 | 0 | 0 | 0 | 0 | 0 | 0 | 0 | 0 | 0 |
| Vacuole | 0 | 0 | 0 | 0 | – | 0 | 0 | 0 | 0 | 0 | 0 | 0 | 0 | 0 | 0 |
External localization resources
Images






























Protein Concentration and Protein Localization Data
| R1 | R2 | R3 | ||||||||||||||||
|---|---|---|---|---|---|---|---|---|---|---|---|---|---|---|---|---|---|---|
| G1 Pre-START | G1 Post-START | S/G2 | Metaphase | Anaphase | Telophase | G1 Pre-START | G1 Post-START | S/G2 | Metaphase | Anaphase | Telophase | G1 Pre-START | G1 Post-START | S/G2 | Metaphase | Anaphase | Telophase | |
| Concentration | -1.2519 | -0.7546 | -0.8876 | -1.274 | -1.1054 | -0.8845 | 0.2282 | 0.5696 | 0.46 | 0.2869 | 0.1525 | 0.422 | 1.4616 | 2.3627 | 2.1956 | 1.497 | 1.8684 | 2.062 |
| Actin | 0.0017 | 0.0006 | 0.0016 | 0.0026 | 0.0009 | 0.0006 | 0.0148 | 0.0088 | 0.002 | 0.0001 | 0.0023 | 0.0003 | 0.0279 | 0.0001 | 0.0219 | 0.0174 | 0.0493 | 0.0069 |
| Bud | 0.0011 | 0.0006 | 0.0001 | 0.0003 | 0 | 0.0001 | 0.0008 | 0.0021 | 0.0023 | 0.0001 | 0.0001 | 0.0001 | 0.0008 | 0 | 0.0008 | 0.0001 | 0.0009 | 0.0012 |
| Bud Neck | 0.0078 | 0.0001 | 0.0001 | 0.0004 | 0.0002 | 0.0003 | 0.0029 | 0.0004 | 0.0001 | 0.0001 | 0.0001 | 0.0002 | 0.0007 | 0 | 0.0009 | 0.0001 | 0.0009 | 0.0002 |
| Bud Periphery | 0.0016 | 0.0004 | 0.0002 | 0.0008 | 0.0001 | 0.0001 | 0.0013 | 0.0054 | 0.0072 | 0.0001 | 0.0002 | 0.0002 | 0.0014 | 0 | 0.0016 | 0.0001 | 0.002 | 0.0033 |
| Bud Site | 0.001 | 0.0014 | 0.0004 | 0.0003 | 0 | 0.0001 | 0.0182 | 0.0092 | 0.0013 | 0 | 0.0003 | 0 | 0.0104 | 0.0001 | 0.0063 | 0.0004 | 0.0021 | 0.0002 |
| Cell Periphery | 0.0001 | 0.0001 | 0.0001 | 0.0001 | 0 | 0 | 0.002 | 0.0004 | 0.0002 | 0 | 0 | 0.0001 | 0.0006 | 0.0001 | 0.0003 | 0 | 0.0005 | 0.0001 |
| Cytoplasm | 0.1488 | 0.2176 | 0.1937 | 0.2058 | 0.2212 | 0.2592 | 0.2425 | 0.3395 | 0.2921 | 0.2902 | 0.4672 | 0.4706 | 0.1213 | 0.2732 | 0.1866 | 0.1876 | 0.285 | 0.2993 |
| Cytoplasmic Foci | 0.0232 | 0.0066 | 0.0093 | 0.0182 | 0.012 | 0.018 | 0.0192 | 0.0053 | 0.0061 | 0.0042 | 0.0121 | 0.0029 | 0.0161 | 0.0022 | 0.011 | 0.0071 | 0.0051 | 0.0087 |
| Eisosomes | 0.0003 | 0.0002 | 0.0009 | 0.0003 | 0.0001 | 0 | 0.0003 | 0.0001 | 0.0001 | 0 | 0 | 0 | 0.0005 | 0.0001 | 0.0005 | 0.0001 | 0.0002 | 0.0001 |
| Endoplasmic Reticulum | 0.002 | 0.0012 | 0.0016 | 0.0045 | 0.0008 | 0.0007 | 0.0031 | 0.0036 | 0.0021 | 0.0007 | 0.0012 | 0.0009 | 0.0066 | 0.0015 | 0.0024 | 0.0041 | 0.0022 | 0.0024 |
| Endosome | 0.0069 | 0.0011 | 0.004 | 0.0058 | 0.0019 | 0.0024 | 0.0104 | 0.0028 | 0.0022 | 0.001 | 0.0294 | 0.0009 | 0.0161 | 0.0005 | 0.0082 | 0.0025 | 0.0208 | 0.0143 |
| Golgi | 0.001 | 0.0001 | 0.0003 | 0.0008 | 0.0001 | 0.0002 | 0.0055 | 0.0028 | 0.0006 | 0 | 0.0136 | 0 | 0.0047 | 0.0001 | 0.005 | 0.0013 | 0.0053 | 0.0053 |
| Lipid Particles | 0.0051 | 0.0003 | 0.0006 | 0.0044 | 0.0002 | 0.0009 | 0.0092 | 0.001 | 0.0009 | 0 | 0.0093 | 0 | 0.0064 | 0.0001 | 0.0063 | 0.0013 | 0.0045 | 0.0063 |
| Mitochondria | 0.0008 | 0.0003 | 0.0004 | 0.0264 | 0.0002 | 0.0003 | 0.0071 | 0.0022 | 0.0008 | 0.0001 | 0.0073 | 0.0001 | 0.0043 | 0.0001 | 0.019 | 0.0004 | 0.0149 | 0.0013 |
| None | 0.782 | 0.7635 | 0.782 | 0.7146 | 0.7598 | 0.709 | 0.6351 | 0.608 | 0.6713 | 0.7016 | 0.4482 | 0.5219 | 0.7505 | 0.7207 | 0.7066 | 0.7546 | 0.5542 | 0.6338 |
| Nuclear Periphery | 0.0038 | 0.0007 | 0.0009 | 0.0039 | 0.0005 | 0.0004 | 0.0058 | 0.0019 | 0.0037 | 0.0003 | 0.003 | 0.0002 | 0.0058 | 0.0003 | 0.0074 | 0.0008 | 0.021 | 0.0057 |
| Nucleolus | 0.0004 | 0.0002 | 0.0002 | 0.0005 | 0.0001 | 0.0001 | 0.0004 | 0.0003 | 0.0002 | 0 | 0.0001 | 0 | 0.0005 | 0 | 0.0005 | 0 | 0.001 | 0.0001 |
| Nucleus | 0.0015 | 0.0024 | 0.0011 | 0.0023 | 0.0006 | 0.0014 | 0.0017 | 0.0023 | 0.0032 | 0.0006 | 0.0008 | 0.001 | 0.0025 | 0.0004 | 0.0038 | 0.0008 | 0.0099 | 0.0011 |
| Peroxisomes | 0.0041 | 0.0002 | 0.0003 | 0.0024 | 0.0001 | 0.0025 | 0.0138 | 0.0012 | 0.0013 | 0.0001 | 0.0014 | 0 | 0.0121 | 0 | 0.0072 | 0.02 | 0.0022 | 0.0074 |
| Punctate Nuclear | 0.0032 | 0.0016 | 0.0011 | 0.0038 | 0.0008 | 0.0031 | 0.0037 | 0.0006 | 0.0013 | 0.0004 | 0.001 | 0.0002 | 0.0049 | 0.0002 | 0.0018 | 0.0005 | 0.0027 | 0.0015 |
| Vacuole | 0.0031 | 0.0006 | 0.0008 | 0.0012 | 0.0004 | 0.0004 | 0.0016 | 0.0017 | 0.0007 | 0.0002 | 0.001 | 0.0003 | 0.0046 | 0.0003 | 0.0012 | 0.0007 | 0.0105 | 0.0005 |
| Vacuole Periphery | 0.0006 | 0.0001 | 0.0001 | 0.0007 | 0.0001 | 0.0001 | 0.0007 | 0.0003 | 0.0002 | 0 | 0.0013 | 0 | 0.0012 | 0 | 0.0007 | 0.0001 | 0.0048 | 0.0003 |
Sequencing Data
| R1 | R2 | |||||||||
|---|---|---|---|---|---|---|---|---|---|---|
| G1 Post-START | S/G2 | Metaphase | Anaphase | Telophase | G1 Post-START | S/G2 | Metaphase | Anaphase | Telophase | |
| Gene Expression | 3.5196 | 17.3048 | 1.1674 | 4.4269 | 2.2817 | 10.553 | 4.7719 | 6.4414 | 6.7247 | 7.2042 |
| Translational Efficiency | – | – | – | – | – | – | – | – | – | – |
Hit Data
| Dataset | Hit |
|---|---|
| Protein Concentration | ✘ |
| Protein Localization | ✘ |
| Gene Expression | ✘ |
| Translational Efficiency | – |
Endocytosis
| Temp | Actin Patch (Sac6-tdTomato) | Cortical Patch (Sla1-GFP) | Late Endosome (Snf7-GFP) | Vacuole (Vph1-GFP) |
|---|---|---|---|---|
| 37℃ | ||||
| RT |
Cell Cycle Omics
CYCLoPs (Jlp2-GFP)
| Gene / Allele | Actin Patch (Sac6-tdTomato) | Cortical Patch (Sla1-GFP) | Late Endosome (Snf7-GFP) | Vacuole (Sac6-tdTomato) |
|---|
| Gene | Images |
|---|
| Gene | Images |
|---|
Images are not yet available
Images are not yet available